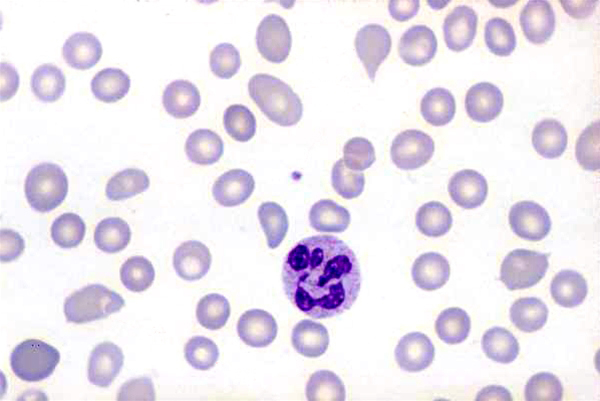
blodceller-makrocytaer anaemi x 100

Perniciøs anæmi
100 x forstørrelse.
Perniciøs anæmi karakteriseret ved usædvanligt store røde blodceller (makrocytære). Her ses desuden stor variation i størrelse og form af de røde blodceller. De hvide blodceller er karakteristisk hypersegmenteret (mere end 5 lapper).
Indhold leveret af
Patienthåndbogen
laegehaandbogen@dadl.dk
Patienthåndbogen
Kristianiagade 12
2100 København Ø
Disclaimer: Patienthåndbogen